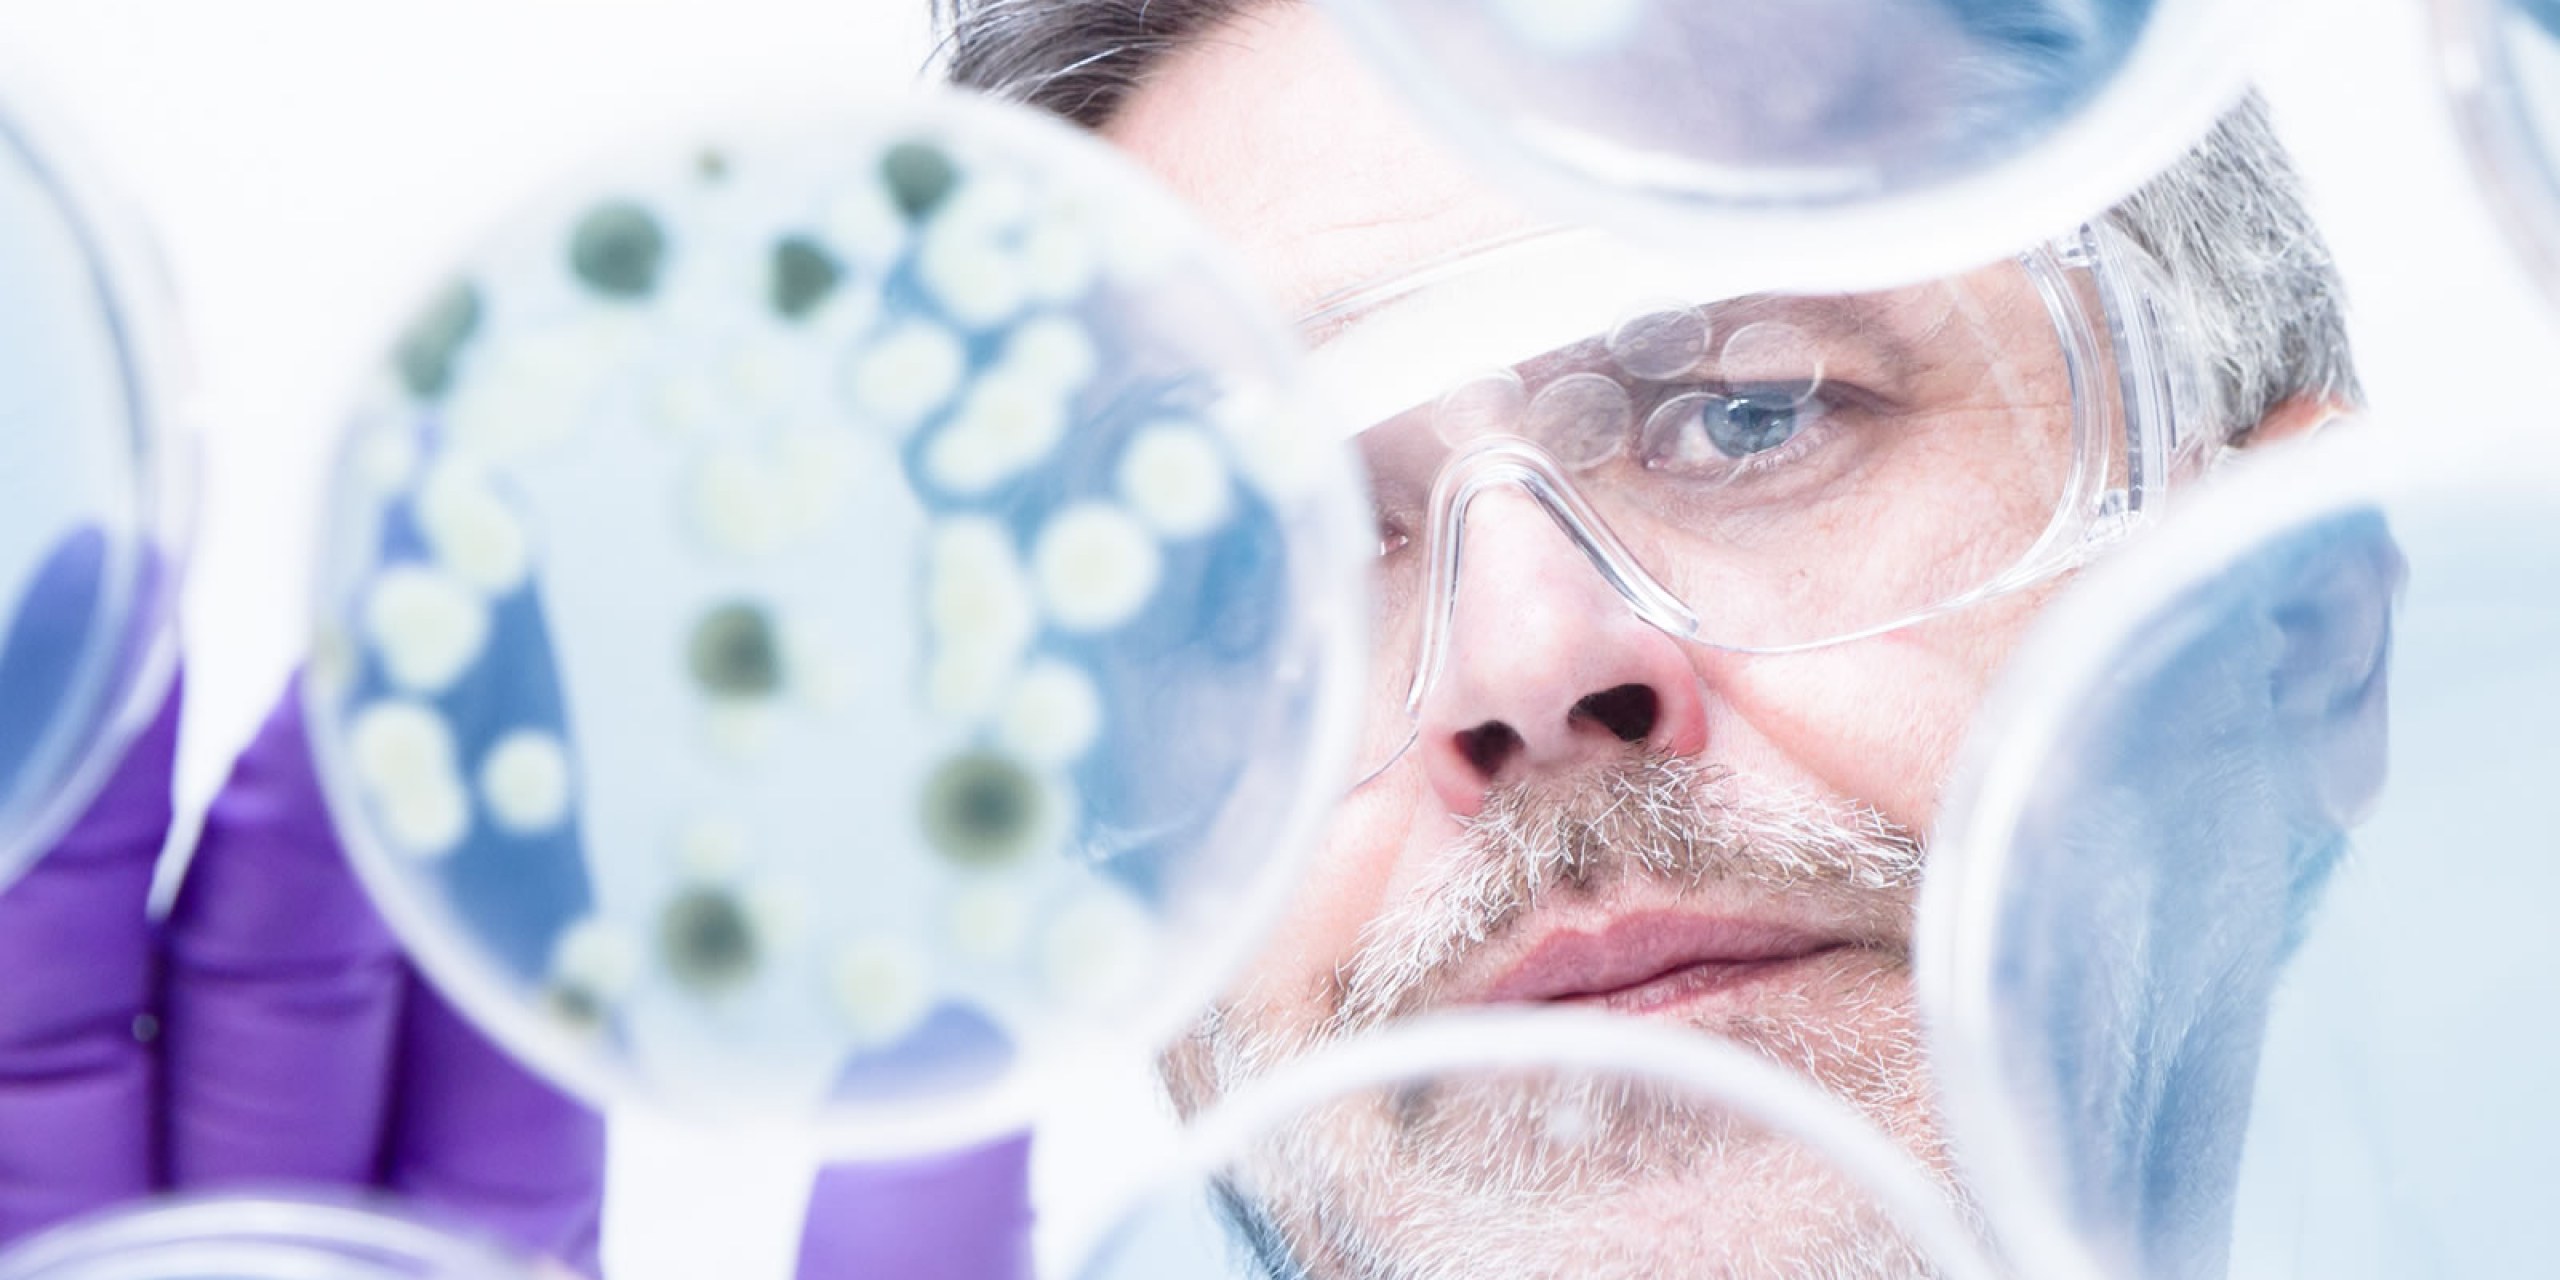

La Fundación QUAES es una organización médica sin ánimo de lucro, que nace de la experiencia y de la visión de un grupo de científicos médicos con una trayectoria consolidada en sector de la genética, el diagnóstico por imagen y tratamientos radioterápicos, que llevan años desarrollando su actividad en centros de prestigio de Madrid, Barcelona y Valencia, teniendo una clara vocación internacional.
Esta Fundación adopta un enfoque integrador con clara visión de futuro, al aglutinar el conocimiento, la capacidad investigadora y el saber científico existentes en el campo de la genómica y del diagnóstico por imagen. Esta integración, absolutamente innovadora en la ciencia de nuestros días, va a permitir a la Fundación QUAES, dotar a los sistemas sanitarios nacionales e internacionales, con los últimos avances científicos en la realización de diagnósticos cada vez más ágiles y precisos, mejorando la calidad de vida de los pacientes.
Nos dedicamos por tanto, a investigar y difundir el conocimiento en materia de diagnósticos de precisión, con el objetivo último de poner los avances científicos, a disposición de la sociedad en general, y del paciente y sus familiares en particular.
La Fundación QUAES dispone de un Patronato en el que se encuentran representadas instituciones universitarias y de investigación, que son referencia en el ámbito de la medicina y la salud.